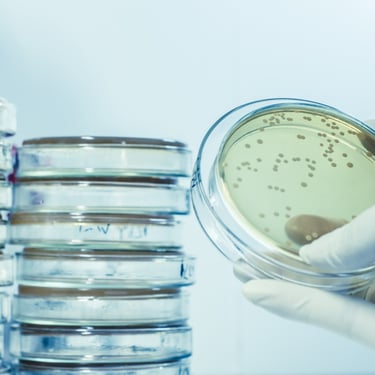

Welcome to MIRANOVA TECHNOLOGIES

UV-C Light Decontamination Specialist.
Professional freelance.
Technology, System Design, Integration and Validation.
18 years of engineering expertise across Pharma, Food and Healthcare.
Bridging technologies between
end-users and suppliers.
In Pharma, Food and Healthcare.
Support for End-users and Machine Builders.

Clean Thinking. Bright Design.
MIRANOVA TECHNOLOGIES
Trelleborggade 8
2150 Nordhavn, Denmark
CVR-number: 46161963
End-Users within the Pharmaceutical, Food or Healthcare Industries.
Translating your biological, functional, capacity, user and quality needs into hard engineering specifications.
Validating technical claims before you commit to a solution, by looking through the engineering reality.
Enforcing physics-based specifications, reviews and compliance from concept to integration and use.
Machine Suppliers: (new or existing projects/systems).
Acting as your on-demand R&D and Compliance resource for UV-C Light: Specs, Design Reviews, Tests.
Providing the simulations, sizing, and validation protocols you need to deliver safe, functional systems.
MIRANOVA TECHNOLOGIES can support you:
